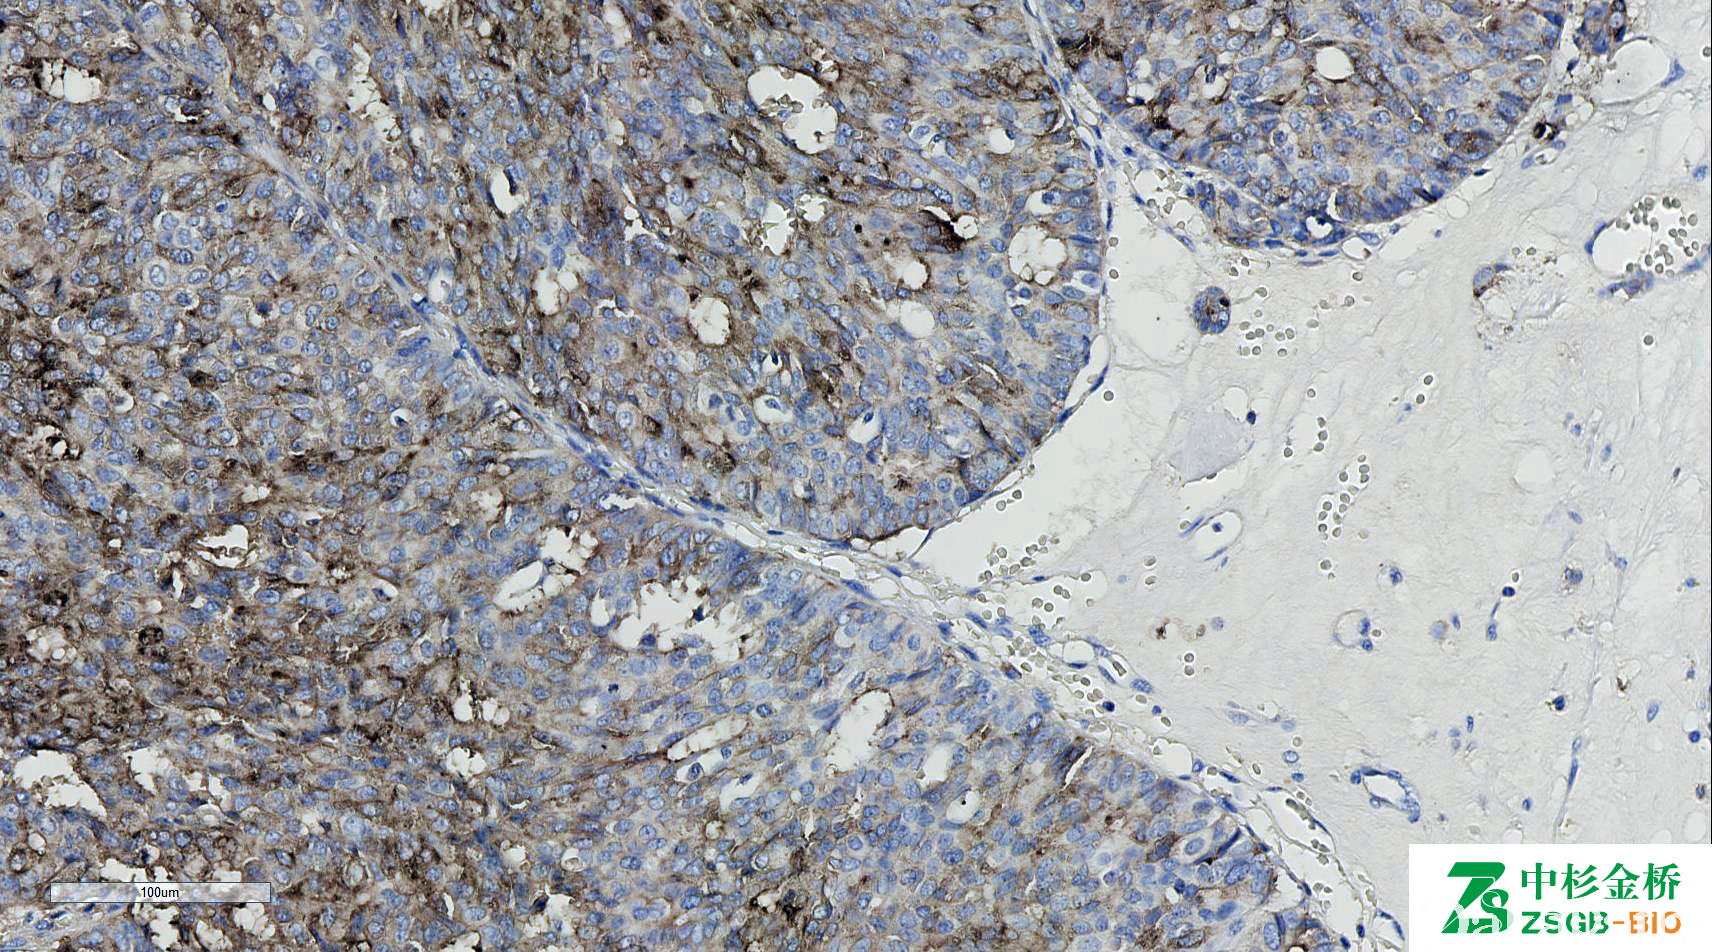

Mammaglobin
别名: MGB1;乳球蛋白
概述:
分泌蛋白家族成员,乳腺相关糖蛋白,由乳腺组织分泌,对乳腺癌组织中的乳腺球蛋白高度敏感(80%)。
信号定位: 胞质
在病理学中的应用:
与 GCDFP15 联合应用用于乳腺癌的鉴别论断。
- Highly specific for most breast cancers; useful to detect circulating or metastatic breast cancer (Arch Pathol Lab Med 2003;127:1330, Int J Clin Exp Pathol 2009;2:384, Mod Pathol 2010;23:654)
- Superior to GCDFP15 (Arch Pathol Lab Med 2008;132:239)
- Positive in endometrial and endocervical specimens (benign and malignant) (Int J Gynecol Pathol 2008;27:418)
- Has limited utility in medullary and metaplastic breast cancers (Am J Clin Pathol 2012;137:747)
- Useful to differentiate mammary analogue secretory carcinoma (MASC) from secretory carcinoma of breast (Hum Pathol 2013;44:1982)
- Useful to differentiate between cutaneous and mammary apocrine carcinomas (Hum Pathol 2014;45:320)
商品化试剂(排名不分先后,本网站对抗体质量不负责!)
公司 | 克隆号 | 即用型(ml) | 原液(ml) | ||||
基因科技 | 304-1A5 | / | 2 | 4 | 7 | / | 0.2 |
赛诺特 | 304-1A5 | 1 | 3 | 6 | / | 0.1 | 0.2 |
中杉金桥 | 304-1A5 | 1.5 | 3 | 6 | / | 0.1 | 0.2 |
EP249 | |||||||
安必平 | 304-1A5&31A5 | 1.5 | 3 | 6 | / | 0.1 | 0.2 |
福建迈新 | 304-1A5 | 1.5 | 3 | 6 | / | / | 0.2 |
在肿瘤中的表达情况:
几乎全部阳性(≥95%的病例阳性): 涎腺类似于乳腺的分泌性癌
通常阳性(<95%,≥75%的病例阳性): 乳腺癌,腔 B 型、乳腺癌,腔 A 型、乳腺浸润性小叶癌、乳腺癌伴印戒细胞样细胞分化
经常阳性(<75%,≥55%的病例阳性): 黏液表皮样癌、皮肤大汗腺腺癌
有时阳性(<55%,≥35%的病例阳性): 腺样囊性癌、乳腺伴大汗腺分化的癌、乳腺浸润性癌,非特殊类型
少数阳性(<35%,≥15%的病例阳性): 膀胱尿路上皮癌、乳腺化生性癌、乳腺导管原位癌、涎腺导管腺癌、乳腺黏液癌、甲状腺腺瘤、乳腺基底样癌,三阴性、涎腺小管腺瘤
偶尔阳性(<15%,≥5%的病例阳性): 结直肠腺癌、胆管癌、子宫内膜腺癌、胃腺癌、胆囊胆管型癌、汗腺癌
几乎全部阴性(<5%的病例阳性): 上皮样间皮瘤、宫颈鳞状细胞癌、甲状腺乳头状癌、食管鳞状细胞癌、肺大细胞癌、耳鼻喉鳞状细胞癌、肺肉瘤样癌、胃印戒细胞癌、食管腺癌、局限性恶性间皮瘤、肺腺鳞癌、肝内胆管细胞癌、宫颈腺癌,非特指型、肺印戒细胞癌、大细胞神经内分泌癌、肺黏液表皮样癌、阑尾印戒细胞癌、乳腺髓样癌、肺腺癌、胰腺导管腺癌